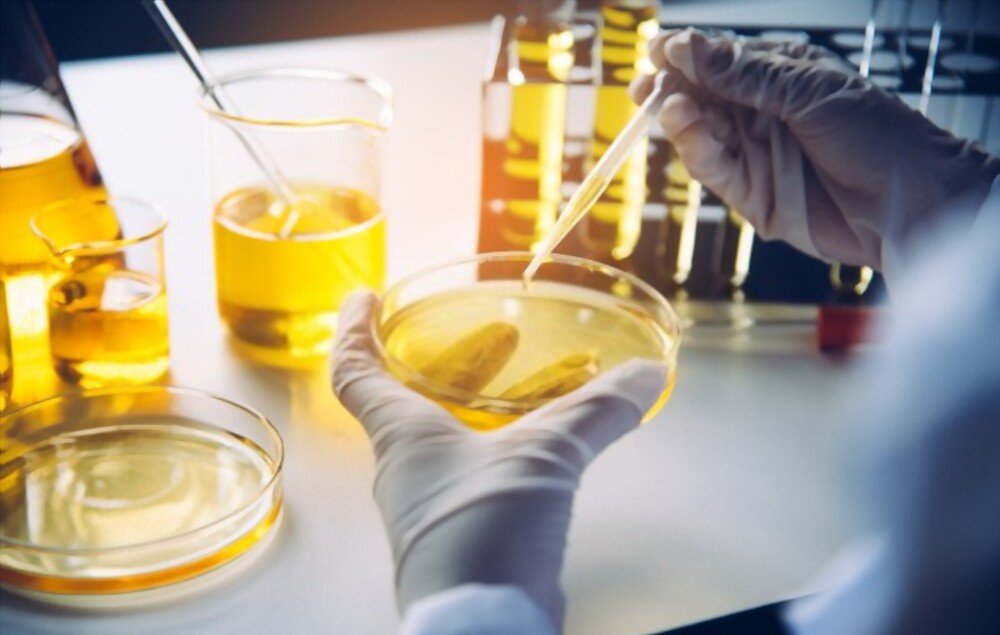

FORMAS DE PAGAMENTO
Exclusivo: Gotas com Extratos de Raízes e Colageno UC2 podem acabar com dores em poucos dias
Solução natural para quem sofre com dores no corpo, artrite, artrose, reumatismo, fibromialgia e etc.
Por G1
02/01/2022 16h58 | Atualizado em: 05/01/2026

- Ingerir apenas 12 gotas por dia dessa substância natural é o suficiente para te devolver uma vida sem dor.
Conforme os anos passam, as famosas dores nas juntas e os incômodos em todo o corpo começam a surgir.
É praticamente inevitável passar uma vida toda imune desses problemas, mas a situação se agrava com o tempo.
Dificuldades para levantar da cama, dores ao caminhar ou praticar algum exercício são um dos exemplos de problemas que as dores nas juntas causam no indivíduo.
A qualidade de vida cai de uma forma acentuada, visto que a pessoa fica impossibilitada de realizar diversas atividades do dia a dia.
Geralmente, a solução encontrada é se entupir de remédios, mas os efeitos colaterais causam outros incômodos.
A situação vira então uma “bola de neve” e, segundo pesquisas, este é um dos principais motivos que levam pessoas a desenvolverem ansiedade e depressão após os 40 anos.

- (Foto: Reprodução/Murilo Serra G1)
Fátima da Conceição, de 47 anos, estava em um momento complicado de sua vida. Desde os 16 ela trabalha como auxiliar de limpeza, mas com o passar dos anos, as dores passaram a lhe incomodar muito.
A dificuldade em realizar algumas atividades eram tantas, que Fátima precisou se afastar do serviço por um período, pois não conseguia limpar a casa de suas clientes.
Consequentemente, passou a deixar de receber seu salário e a situação financeira começou a ficar ainda mais complicada.
Ela precisava de uma solução que fosse eficiente, mas também rápida para voltar a trabalhar.
Foi então que, em buscas na internet, ela encontrou o que parecia ser sua salvação.
Depois de ingerir diversos antibióticos e gastar um bom dinheiro com remédios, ela encontrou uma fórmula que parecia ser eficiente.
“Eu confesso que não estava 100% confiante com a eficiência do produto, pois parecia bom demais para ser verdade. Mas eu precisava testar, estava desesperada, e em poucos dias minhas dores sumiram”.
Fátima passou a ingerir o produto natural: CCY Gotas. Em questão de horas, os efeitos foram percebidos pela auxiliar de limpeza, que conseguiu voltar ao serviço no dia seguinte.
Sua artrose, que tanto estava lhe incomodando, sumiu de uma hora para outra.
“Os efeitos foram mais rápidos do que eu imaginava. De verdade, se me contassem, eu não acreditaria que era tão bom. Só acredito, porque aconteceu comigo”.

A solução dos sonhos!
Depois de começar a ingerir o CCY Gotas , Fátima passou a se perguntar sobre como o produto conseguia ser tão eficiente.
“Queria entender como que apenas ao ingerir a fórmula uma vez por dia, eu conseguia me afastar das dores e não sentir mais nenhum incômodo”.
Ela então pesquisou a fundo sobre o processo de produção da fórmula e sobre seu criador.
Em suas buscas na internet, a auxiliar de limpeza descobriu que cientistas sérvios resolveram estudar a fundo as causas e consequências desses incômodos no corpo.
A cada ano, o número de pessoas que iam ao médico em virtude das dores no corpo aumentava.
E o grande problema é que os jovens também começaram a sentir os efeitos negativos desses incômodos nas juntas, lombar e costas.
Então, o cientista Goran Ivanović realizou uma pesquisa com mais de 5 mil voluntários e desenvolveu um creme capaz de aliviar as dores em poucos dias: o Curcumed.
A questão é que a eficiência do produto foi tanta, que clientes passaram a pedir para o cientista desenvolver a fórmula em gotas, para acelerar ainda mais os resultados.
Ivanović então fabricou o CCY Gotas, um remédio em gotas, que traz alívio imediato, pois libera o efeito de seus componentes de dentro para fora.
Mas por que o CCY Gotas é tão eficiente?
O CCY Gotas contém poderosos anti-oxidantes e anti-inflamatórios naturais, como extrato glicólico de extrato de cúrcuma longa e zingiber.
Ambos agem diminuindo as inflamações internas e aceleram o processo de regeneração das células, consequentemente diminuindo as dores no corpo e articulações.
Por ser 100% natural, a fórmula é mais eficiente do que outros produtos que existem no mercado e que prometem te fazer chegar ao corpo dos sonhos.
Mas por que a maioria dos produtos não possuem resultados tão bons quanto o CCY Gotas?
Pois a indústria farmacêutica não quer que a população se alivie das dores.
Pensa bem: o quanto as grandes empresas deixariam de lucrar se as pessoas deixassem de sentir esses incômodos no corpo?
A maioria iria parar de comprar remédios e encapsulados que a indústria farmacêutica produz e que garantem um lucro gigantesco.
Por isso, a ideia de Ivanović ao elaborar o CCY Gotas foi justamente ao contrário.
Ele conseguiu reunir os principais produtos naturais, que combatem diretamente as dores de dentro para fora. Em sua composição, a fórmula possui:
• EXTRATO DE CÚRCUMA LONGA
Um dos remédios naturais mais potentes para o tratamento das dores nas articulações.

• ZINGIBER OFFICINALE
Tem ação anti-inflamatória e calmante, melhorando os sintomas de dor em pessoas com artrite, reumatismo e artrose e outros.
• COLÁGENO TIPO II
Ele atua na reposição do colágeno perdido nas articulações e combate o processo inflamatório nessas regiões.
Conclusão: Vale a pena comprar esse famoso produto que acaba com as dores?
Opinião da Jornalista: Hoje em dia, graças a esse produto americano, a pessoa que deseja ter uma vida sem dor só não tem se realmente não quer.
Como me incluo nesse número de pessoas que tem muita dor, resolvi fazer a compra de 3 frascos do produto, para utilizar durante 3 meses.
O produto chegou em 10 dias, via Correios (na minha região), numa embalagem muito protegida.
Pois bem, não poderia indicar o produto sem antes testar! Experimentei e conferi os resultados! E agora que confio no produto e na empresa, consegui uma parceria com preço especial, e todos os nossos leitores terão 50% de desconto se comprar HOJE
Isso mesmo, somente comprando HOJE, você tem 50% de desconto nesta novidade que está chegando no Brasil.
Livre-se da dor de forma fácil, segura e econômica
O CCY Gotas tem uma formulação exclusiva desenvolvida nos Estados Unidos e antes dessa parceria da empresa americana com o Brasil só era possível comprar este famoso creme via importação, o que tornava o produto muito caro! Cerca de 400 reais a unidade.
Com a fabricação no Brasil já é possível encontrar esse produto em parcelas de menos de 20 reais por mês! Hoje o tratamento está muito acessível a toda a população.
Espero ter ajudado vocês com a publicação dessa matéria e com o meu relato. Também gostaria de agradecer publicamente o desconto de 50% fornecido pela empresa do CCY Gotas para nossos leitores.
OBSERVAÇÃO: Essa oferta é válida somente para as 50 primeiras pessoas que apertarem no botão abaixo para adquirir:
108 COMENTÁRIOS
Os comentários são de responsabilidade exclusiva de seus autores e não representam a opinião deste site. Se achar algo que viole os termos de uso, denuncie. Leia as perguntas mais frequentes para saber o que é impróprio ou ilegal.

Luana Soares
Há 1 dia
Eu estava no aguardo de um produto assim, e finalmente lançaram. Vou aproveitar que está na promoção e comprar vai que o preço aumenta, estamos no Brasil ne hahahah
Rubens Sales
Há 1 dia
Comprei pra mim e chegou tudo certo aqui em Recife, sempre desconfio em comprar na internet, mas esse foi o único confiável pra mim. Estou amando minha vida sem dor.

Mayara Almeida
Há 1 dia
Obrigada por comentar Rubens, eu vi na internet e estava meio desconfiada mas depois que você falou, e lendo os comentários aqui, vi que o negocio funciona mesmo, vou pedir o meu hoje.
Gabriela Oliveira
Há 3 dias
Estou tomando há 2 semanas. Estava prestes a fazer uma cirurgia na coluna, passei uma pomada que o médico passou mas nada resolveu, resolvi arriscar o CCY Gotas e após o terceiro dia de uso já não sentia mais nada, obrigado CCY Gotas .

Ana Flávia
Há 3 dias
Sério? Eu ja estou desesperada kkkk, sinto que tenho que experimentar isso, mas será que funciona pra fibrobialgia? já não aguento mais kkkkk
Maria Fernanda
Há 3 dias
Amiga, funciona sim, também não aguentava mais de tanta dor, uso desde quando lançou aqui no brasil e foi o unico que funcionou comigo. eu comprei nesse site aqui https://ccygotas.com.br/
Este conteúdo não recebe mais comentários
globo.com | g1 | globoesporte | gshow | famosos | vídeos | todos os sites
G1
© Copyright 2000-2020 G1 Participações S.A.

